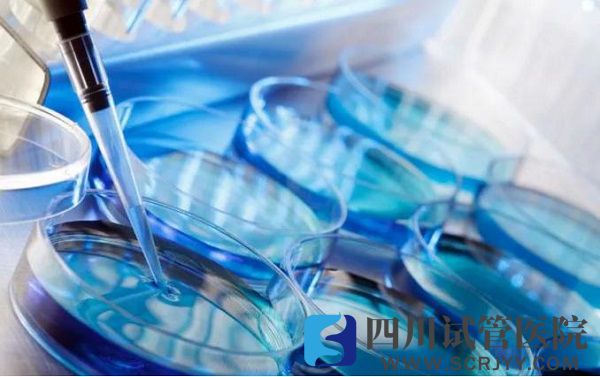
西北妇女儿童医院试管成功率在52%左右

陕西省妇幼保健院
西北妇女儿童医院开展常规体外授精-胚胎移植,显微取精、单精子卵胞浆内显微注射,胚胎种植前遗传学诊断,未成熟卵体外培养、人工授精(丈夫精液或供精)、男女不孕症及复发性流产、生殖内分泌疾病治疗等技术,是陕西地区两家支持第三代试管婴儿技术的医院之一。本文将围绕西北妇女儿童医院挂号、收费、成功率、技术水平等收集、整理成文,为更多不孕不育家庭在医院选择上提供参考。

陕西省妇幼保健院
了解西北妇女儿童医院生殖中心
西北妇女儿童医院,亦称为陕西妇幼保健院,位于中国陕西西安新城区后宰门73号(后宰门院区),现医院院长为李亚军教授,是陕西省内试管婴儿量最大的中心,每月接待患者2万余人次。陕西省卫生厅批准建立陕西省唯一一家人类精子库,目前库存精液标本3万余份,在西北地区率先开展显微取精手术,目前国内仅有数家医院开展此手术,且西北妇女儿童医院已经完成126例手术。

西北妇女儿童医院门诊部
医院背景与历史发展
医院创建于1974年,陕西省妇产科学会、省计划生育研究所、省辅助生殖技术中心、省产前诊断中心、省新生儿疾病筛查中心、省新生儿急救中心、省托幼保育中心均设于院内。1993年被卫生部、世界卫生组织首批授予“爱婴医院"称号,并于2008年以来先后被评为全国精神文明建设先进单位,全国首批院务公开示范点,2012年挂牌成立了“陕西省妇幼保健院技术协作医院",后改名为西北妇女儿童医院。
西北妇女儿童医院是西部地区服务能力最强、技术最好的生殖中心。截止2021年7月底,中心完成IVF/ICSI周期3万余例,近3年间通过体外授精胚胎移植技术共出生男婴4052名、女婴4047名,且完成供精人工授精2020余例。开展全部种类的辅助生殖技术,去年完成试管婴儿14434个周期,同比增长25.27%,平均临床妊娠率62%,业务量居全国辅助生殖中心第6位。
西北妇女儿童医院试管婴儿费用明细
西北妇女儿童医院可支持的试管婴儿技术较多,且是一所公立性质的医院,因此其试管婴儿手术收费不会太贵,且是相对比较公开透明的。一般在西北妇女儿童医院做试管婴儿的费用大概在3-10万元左右。因为每个人的身体情况、治疗方案都不同,所以做试管婴儿的具体费用也会有所差异,其中做第三代试管婴儿的价格会更贵点,具体如下。
- 1. 按照平均水平估算,1次常规体外授精(第一代试管婴儿)+1次新鲜胚胎移植+冷冻保存费用=大致为30000左右元;
- 2. 西北妇女儿童医院行单精子卵胞浆内显微注射(第二代试管婴儿)费用相较常规体外授精增加5000元;
- 3. 1次供精体外授精-胚胎移植相较常规IVF增加6500元标本费;
- 4. 第三代试管婴儿相较二代试管婴儿增加活检费3000元及胚胎检测费2850元/胚胎。
在试管婴儿治疗的过程中,有的姐妹比较年轻,卵巢功能好,可能用一些促排药,卵泡就能发育得很好,一个月经周期内就能排出很多卵子,这样试管婴儿的药物费用就会少一些。而一些姐妹年龄比较大,卵巢反应差,打常规的剂量促不起来,可能就要加量或者换药,这个药物费用肯定会贵很多。

不同试管方案收费不同
但总的来说,西北妇女儿童医院试管婴儿收费在全国范围内算是比较便宜的,且该院支持三代试管婴儿技术,所以相对平均收费比部分医院要贵一些。因为要做第三代试管婴儿的话,还得多出一笔胚胎筛查的费用,有需求还得多一笔养囊的费用、胚胎冷冻和胚胎保存管理的费用,这样就直接拉高了整个医院平均试管婴儿收费。
试管婴儿成功率
根据以往的数据来看,西北妇女儿童医院试管婴儿算是比较高的,近年来,该院生殖中心全年门诊量42万人次,完成试管婴儿治疗近两万余例,其中鲜胚移植一万余例,冻融胚胎周期六千多例,平均临床妊娠率52%左右。但并不表示每个人在该院做试管婴儿就一定会成功,因为做试管的成功率跟患者的身体情况有关,如果患者的身体情况较好,那试管婴儿助孕的成功率也比较高。
陕西省妇幼保健院试管婴儿成功率较高
目前来看如果是正常的女性,体内的胚胎着床率相对来说还是比较高的,基本上着床率相对较高,就能让整个试管婴儿成功率提升,但是如果是输卵管有积水或者是输卵管堵塞,那么这种情况下会对着装率产生影响,所以女性的身体素质非常重要。
总体来说,西北妇女儿童医院试管婴儿成功率还是比较高的,可支持的试管技术也比较多。包括夫精人工授精(AIH)、供精人工授精(AID)、体外受精-胚胎移植(IVF-ET)、配子或合子输卵管内移植(GIFT或ZIFT)、卵胞浆内单精子显微注射(ICSI)、胚胎冻融(CET/FET)、植入前胚胎遗传学诊断(PGD)等,满足各类不孕夫妇的需求。
好评医生推荐
西北妇女儿童医院生殖中心临床医学、遗传咨询、实验室有柏海燕(副主任医师)、王涛(副主任医师)、田莉(副主任医师/讲师)、龚世珣(主任医师/教授)、马淳(主任医师)等生殖医学专家共计33位。
王涛
柏海燕
田莉
西北妇女儿童医院经验互助
对于大部分人来说,费用、流程、成功率、医生等相关问题是普通人了解试管婴儿医院恒久不变的话题,通过以下问题有助于你更全面的了解陕西省妇幼保健院(西北妇女儿童医院),更有试管婴儿医生专业解答,以窥见陕西试管婴儿一隅。
- 1. 谁有陕西省妇幼保健院试管婴儿的明细表?
- 2. 陕西省妇幼保健院试管婴儿做的好的医生有哪些?
- 3. 西北妇女儿童医院试管婴儿成功率高不高?
- 4. 陕西省妇幼保健院试管婴儿技术怎么样?
- 5. 西北妇女儿童医院试管婴儿多少钱?
- 6. 西北妇女儿童医院试管婴儿挂什么科?
- 7. 陕西省妇幼保健院试管婴儿流程是怎样的?





